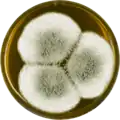

Aspergillus giganteus
Aspergillus giganteus is a species of fungus in the genus Aspergillus (from Latin "aspergillum," meaning "holy water sprinkler") that grows as a mold.[2] It was first described in 1901 by Wehmer,[1] and is one of six Aspergillus species from the Clavati section of the subgenus Fumigati.[3] Its closest taxonomic relatives are Aspergillus rhizopodus (Rai et al., 1975)[4][3] and Aspergillus longivescia (Huang and Raper, 1971).[5][3]
| Aspergillus giganteus | |
|---|---|
| Scientific classification | |
| Kingdom: | Fungi |
| Division: | Ascomycota |
| Class: | Eurotiomycetes |
| Order: | Eurotiales |
| Family: | Trichocomaceae |
| Genus: | Aspergillus |
| Species: | A. giganteus |
| Binomial name | |
| Aspergillus giganteus Wehmer (1901)[1] | |
Morphology

Like the majority of Aspergillus species,[6] A. giganteus reproduces asexually, and has not been observed in a sexual state.[3] Similar to other species in Clavati, A. giganteus produces numerous conidiophores that are characterized by glassy and translucent stem-like structures called stipes and club-shaped aspergilla that taper towards the tips.[3] Blue-green colored asexual spores called conidia form on these tips.[3]
On a macroscopic level, A. giganteus colonies are characterized by their velvety texture.[3] Colonies are often white at first, turning a pale blue-green color when exposed to light.[3]

On a microscopic level, A. giganteus produces two types of conidiophores that have distinct stipes and vesicles. The first of these conidiophores are typically 2-3 mm tall, including stipe length.[3] These shorter conidiophores produces clavate vesicles that are 100-250 μm long and 30-50 μm wide.[3] The second type of conidiophores are much larger, approximately 1-5 cm long.[3] Most of this length is due to elongated stipes.[3] These more elongated conidiophores are phototropic, meaning that they are only able to develop and grow in the presence of light.[3] The vesicles produced by the long conidiophores are 400-600 μm long and 120-180 μm wide, more than double the size of the vesicles produced by their shorter counterparts.[3]
Together the vesicle and phialides form the conidial head. In A. giganteus, these heads are blue-green in color, and split into two or more columns as the mold matures.[3] Conidia form from these conidial heads. The conidia of A. giganteus are relatively thick-walled, and are distinguishable by their smooth, elliptical appearance as well as their size (3.5-4.5 x 2.4-3.0 μm). These traits are characteristic of both types of conidiophore.[3] A. giganteus can be distinguished form other Aspergillus species placed within the Clavati section by its microscopic morphology and by its unique combination of extrolites, which are compounds synthesized by and then excreted by cells in defense against bacteria and other fungi.[3][8] Morphologically, A. giganteus lacks the rhizoidal foot cells present in A. rhizopodus, and has clavate vesicles that stand in contrast to the elongated vesicles of A. longivesica.[3] In terms of extrolite synthesis, although A. giganteus produces mycotoxins and antibiotics that are characteristic of all Clavati section species (such as patulin,[8] tryptoquivalines and tryptoquivalones,[3] and alpha-sarcins),[9] it also produces extrolites not synthesized by its closest relatives. These include several different carotinoids[10] and penicillin-like clavinformin.[11]
Ecology
A. giganteus is found worldwide, and has been officially documented in Nigeria, the United States, Egypt, Mexico, Panama, Germany, Suriname, the Netherlands, and Poland.[3] It is most often dung-borne, but will grow in alkaline soil and wood substrates.[3] As a saprotrophic mold,[2] A. giganteus gets its energy by absorbing nutrients from the substrates it grows in. Although many other Aspergillus and Clavati section species are known pathogens of humans, A. giganteus does not have any reported pathogenic effects.[3]
In the lab, A. giganteus has been cultivated on both Czapek yeast extract agar (CYA) plates and Malt Extract Agar Oxoid® (MEAOX) plates,[3] as shown below.
 Aspergillus giganteus growing on CYA plate
Aspergillus giganteus growing on CYA plate Aspergillus giganteus growing on MEAOX plate
Aspergillus giganteus growing on MEAOX plate
Economic relevance
Antifungal protein (AFP)
A. giganteus produces an antifungal protein (AFP) that has potential applications for preventing fungal infection in both pharmaceutical and agricultural settings. AFP has been shown to restrict the growth of numerous economically-important filamentous fungi.[12] These include Aspergillus fumigatus, the main cause of aspergillosis in humans,[12] and other Aspergillus species;[13] Fusarium oxysporum and related Fusarium species,[12] common pathogens of tomato, bean, banana, melon, cotton, and chickpea plants;[14] Magnaporthe grisea, a pathogen of rice and cereal crops;[2] and Botrytis cineara, pathogenic to geranium and other economically important ornamental plants.[15] Additionally, AFP may restrict the growth of the oomycete Phytopthera infestans,[2] the pathogen infamous for causing late blight in potatoes (the main cause of the Great Famine of Ireland) and tomatoes.[16]
In additional to having high potential for success in combatting the infections listed above, AFP does not inhibit the viability of yeast, bacteria, mammalian,[17] or plant cells.[18] Because there are many filamentous fungal species that do not respond to AFP, it is likely that the protein's detrimental effects are species-specific.[13][19] As such, AFP could be used to treat and prevent infection by very specific pathogens without harm to patients or host plants. Furthermore, the protein can be easily synthesized through fermentation of A. giganteus and is resistant to hear. In comparison to other antifungal treatments, small amounts of the protein are needed to prevent the growth of harmful pathogens.[20] In combination with the fact that AFP almost completely blocks growth of sensitive, pathogenic fungi (unlike the ozone, hydrogen peroxide, and chlorine dioxide antifungal treatments currently used in agricultural systems,)[18] these factors highlight AFP's potential as a cheap, mass-producible, and extremely effective solution to pathogen infection.
AFP mode of action
The cysteine-rich,[20] amphipathic[13] protein inhibits the growth of AFP-senstivie pathogens through multiple pathways. First, AFP may inhibit cell growth by inhibiting chitin synthesis.[12] In sensitive fungi, AFP activates the cell wall integrity pathway, thereby enhancing the expression of the α-1,3-glucan synthase A gene responsible for remodeling cell walls and inhibiting the formation of chitin.[21] AFP may also alter the cell membrane permeability of sensitive fungi,[19] particularly of Aspergillus niger,[13] or cause an immediate, sustained increase in calcium cation cell resting potential that often results in programmed cell death.[21] Each of these pathways ultimately results in the death of the AFP-sensitive pathogen. Although more research is needed to identify how these pathways work in consort, the wide variety of AFP modes of action highlights that the protein may interact with sensitive pathogens in different ways, that these pathogens vary in their susceptibility to AFP.[13]
Preliminary studies on applications of AFP
In preliminary studies on the pharmaceutical and agricultural applications of AFP, researchers used AFP to halt the growth of Phytopthera infestans[2] and Aspergillus species[12][13][19] in culture. In applying AFP solutions to plant leaves and roots, infections by Botrytis cineara in geranium plants[15] and Magnaporthe grisea in rice plants were eliminated.[2] In each of these cases, AFP caused deformations in the hyphae of the sensitive fungi, resulting in reduced hyphal elongation and inability of the pathogen to grow.[2][15] In addition to direct application to plant structures, the AFP-encoding gene can be edited into the genomes of the plants affected by the AFP-sensitive fungi such that the plants are able to synthesize the protein on their own.[22][23][24] This technique has been successfully used to decrease infection by Puccinia substriata, the main cause of rust disease, and Sclerospora graminicola, a causal agent of downy mildew, in pearl millet plants,[22] as well as infection by Magnaporthe grisea in rice plants.[23][24] Although genetic enhancement halted infection in laboratory and greenhouse settings, researchers continue to debate about the scalability of plant genome editing and the ability of plants themselves to synthesize enough AFP to fight off pathogen infection in the field.[23][24]
References
- Wehmer 1901, Mem. Soc. Phys. Genève 33(2): 85
- Vila L, Lacadena V, Fontanet P, Martinez del Pozo A, San Segundo B (November 2001). "A protein from the mold Aspergillus giganteus is a potent inhibitor of fungal plant pathogens". Molecular Plant-Microbe Interactions. 14 (11): 1327–31. doi:10.1094/MPMI.2001.14.11.1327. PMID 11763131.
- Varga J, Due M, Frisvad JC, Samson RA (2007). "Taxonomic revision of Aspergillus section Clavati based on molecular, morphological and physiological data". Studies in Mycology. 59: 89–106. doi:10.3114/sim.2007.59.11. PMC 2275193. PMID 18490946.
- Rai JN, Wadhwani K, Agarwal SC (June 1975). "Aspergillus rhizopodus sp.nov. from Indian alkaline soils". Transactions of the British Mycological Society. 64 (3): 515–517. doi:10.1016/s0007-1536(75)80153-7. ISSN 0007-1536.
- Huang LH, Raper KB (January 1971). "Aspergillus Longivesica, a New Species from Nigerian Soil". Mycologia. 63 (1): 50–57. doi:10.1080/00275514.1971.12019081. ISSN 0027-5514.
- Dyer PS, Paoletti M (May 2005). "Reproduction in Aspergillus fumigatus: sexuality in a supposedly asexual species?". Medical Mycology. 43 Suppl 1 (s1): S7-14. doi:10.1080/13693780400029015. PMID 16110786.
- "Aspergillus". Mycology Online. The University of Adelaide. Retrieved 2019-05-17.
- Varga J, Rigó K, Molnár J, Tóth B, Szencz S, Téren J, Kozakiewicz Z (2003). "Mycotoxin production and evolutionary relationships among species of Aspergillus section Clavati". Antonie van Leeuwenhoek. 83 (2): 191–200. doi:10.1023/A:1023355707646. PMID 12785313.
- Lin A, Huang KC, Hwu L, Tzean SS (January 1995). "Production of type II ribotoxins by Aspergillus species and related fungi in Taiwan". Toxicon. 33 (1): 105–10. doi:10.1016/0041-0101(94)00140-4. PMID 7778122.
- van Eijk GW, Mummery RS, Roeymans HJ, Valadon LR (1979-09-01). "A comparative study of carotenoids of Aschersonia aleyroides and Aspergillus giganteus". Antonie van Leeuwenhoek. 45 (3): 417–422. doi:10.1007/BF00443280. ISSN 1572-9699. PMID 554534.
- Florey HW, Jennings MA, Philpot FJ (January 1944). "Claviformin from Aspergillus giganteus Wehm". Nature. 153 (3874): 139. Bibcode:1944Natur.153..139F. doi:10.1038/153139a0.
- Hagen S, Marx F, Ram AF, Meyer V (April 2007). "The antifungal protein AFP from Aspergillus giganteus inhibits chitin synthesis in sensitive fungi". Applied and Environmental Microbiology. 73 (7): 2128–34. doi:10.1128/AEM.02497-06. PMC 1855660. PMID 17277210.
- Meyer V (February 2008). "A small protein that fights fungi: AFP as a new promising antifungal agent of biotechnological value". Applied Microbiology and Biotechnology. 78 (1): 17–28. doi:10.1007/s00253-007-1291-3. PMID 18066545.
- Michielse CB, Rep M (May 2009). "Pathogen profile update: Fusarium oxysporum". Molecular Plant Pathology. 10 (3): 311–24. doi:10.1111/j.1364-3703.2009.00538.x. PMC 6640313. PMID 19400835.
- Moreno AB, Del Pozo AM, Borja M, Segundo BS (November 2003). "Activity of the Antifungal Protein from Aspergillus giganteus Against Botrytis cinerea". Phytopathology. 93 (11): 1344–53. doi:10.1094/PHYTO.2003.93.11.1344. PMID 18944061.
- Barkai-Golan R (June 2001). Postharvest Diseases of Fruits and Vegetables (1st ed.). Elsevier. ISBN 978-0-444-50584-2.
- Szappanos H, Szigeti GP, Pál B, Rusznák Z, Szucs G, Rajnavölgyi E, Balla J, Balla G, Nagy E, Leiter E, Pócsi I, Hagen S, Meyer V, Csernoch L (July 2006). "The antifungal protein AFP secreted by Aspergillus giganteus does not cause detrimental effects on certain mammalian cells". Peptides. 27 (7): 1717–25. doi:10.1016/j.peptides.2006.01.009. PMID 16500727.
- Barakat H, Spielvogel A, Hassan M, El-Desouky A, El-Mansy H, Rath F, Meyer V, Stahl U (June 2010). "The antifungal protein AFP from Aspergillus giganteus prevents secondary growth of different Fusarium species on barley". Applied Microbiology and Biotechnology. 87 (2): 617–24. doi:10.1007/s00253-010-2508-4. PMID 20217075.
- Theis T, Wedde M, Meyer V, Stahl U (February 2003). "The antifungal protein from Aspergillus giganteus causes membrane permeabilization". Antimicrobial Agents and Chemotherapy. 47 (2): 588–93. doi:10.1128/aac.47.2.588-593.2003. PMC 151754. PMID 12543664.
- Lacadena J, del Pozo AM, Gasset M, Patino B, Campos-Olivas R, Vazquez C, et al. (December 1995). "Characterization of the Antifungal Protein Secreted by the MouldAspergillus giganteus". Archives of Biochemistry and Biophysics. 324 (2): 273–81. doi:10.1006/abbi.1995.0040. PMID 8554319.
- Binder U, Bencina M, Eigentler A, Meyer V, Marx F (September 2011). "The Aspergillus giganteus antifungal protein AFPNN5353 activates the cell wall integrity pathway and perturbs calcium homeostasis". BMC Microbiology. 11 (1): 209. doi:10.1186/1471-2180-11-209. PMC 3197501. PMID 21943024.
- Girgi M, Breese WA, Lörz H, Oldach KH (June 2006). "Rust and downy mildew resistance in pearl millet (Pennisetum glaucum) mediated by heterologous expression of the afp gene from Aspergillus giganteus". Transgenic Research. 15 (3): 313–24. doi:10.1007/s11248-006-0001-8. PMID 16779647.
- Coca M, Bortolotti C, Rufat M, Peñas G, Eritja R, Tharreau D, del Pozo AM, Messeguer J, San Segundo B (January 2004). "Transgenic rice plants expressing the antifungal AFP protein from Aspergillus giganteus show enhanced resistance to the rice blast fungus Magnaporthe grisea". Plant Molecular Biology. 54 (2): 245–59. doi:10.1023/B:PLAN.0000028791.34706.80. PMID 15159626.
- Moreno AB, Peñas G, Rufat M, Bravo JM, Estopà M, Messeguer J, San Segundo B (September 2005). "Pathogen-induced production of the antifungal AFP protein from Aspergillus giganteus confers resistance to the blast fungus Magnaporthe grisea in transgenic rice". Molecular Plant-Microbe Interactions. 18 (9): 960–72. doi:10.1094/MPMI-18-0960. PMID 16167766.